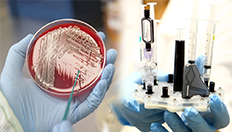

MEDICA 2019
Wann: 18.-21. November 2019
Wo: Düsseldorf
Branchen:
Medizintechnik, Gesundheit, Pharmazie, Pflege, Zulieferwirtschaft
Angebotsschwerpunkte:
Arzneimittel, Ärztliche Instrumente, Chirurgischer Bedarf, Diagnostika, Dienstleistungen, Elektromedizin, Fachpublikationen, Hygiene, Kommunikationsmittel, Krankenhausausrüstung, Krankenhausbedarf, Krankenhauseinrichtungen, Krankenhausmanagement, Laboreinrichtungen, Laborgeräte, Laborinstrumente, Labortechnik, Medizinische Geräte, Medizintechnik, Orthopädietechnik, Pharmazeutika, Physiotherapie, Praxisbedarf, Praxiseinrichtungen, Reagenzien, Röntgengeräte für medizinische Zwecke, Sanitätsbedarf, Therapeutika, Tiermedizin, Zulieferindustrie
Standort des Messestandes
Halle 3 | Stand D94